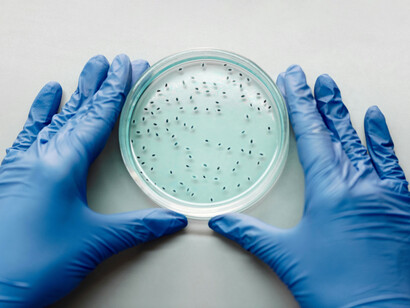
Aunque algunas bacterias causan enfermedades, la mayoría cumple funciones beneficiosas en el cuerpo humano y en la naturaleza
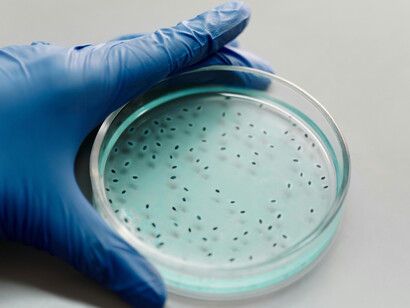
Las bacterias son organismos unicelulares muy antiguos y diversos, esenciales para muchos procesos ecológicos

Mis primeros recuerdos de microbiología se remontan a la Universidad de Oriente en Cumana a finales de la década de 1980. La teoría me sentaba bien, sin embargo, el laboratorio era un desastre total, mis cultivos en placas de Petri salían todos contaminados demostrando que el mundo bacteriano es muy diverso y omnipresente.
Esta anécdota personal confiesa una falta de meticulosidad ante lo sensible que es el medio ambiente, incluso de laboratorio, y su miríada de microorganismos. Evidentemente lo que me sucedía era que dejaba mucho tiempo abierta las placas fuera de la cámara axénica de los cultivos, respiraba sobre estas, o quizás otro descuido menor, pero grave. Poco a poco mis placas de Petri mejoraron, mas no así me demostraron que el universo microbiano no era mi futuro en el área.
Fuera del laboratorio, imaginen la millonada de organismos que nuestros ojos no pueden observar, más aquello que nuestro cuerpo es afectado por ellos. Específicamente quiero hablar de uno de los microbios más pequeños y con peor fama que son las bacterias. Cuando en realidad más son las beneficiosas que los perjuicios.
Las bacterias son organismos de una sola célula, aunque pueden formar colonias que logran vivir agregadas. Esas células son procariotas, es decir no tienen membrana nuclear. Para especificar mejor, su material genético está disperso en toda la célula y no confinado a un núcleo como la mayoría de las células eucariotas de la mayoría de los seres vivos que conocemos. Es casi seguro que las bacterias fueron los primeros seres vivos de la tierra hace más de 4000 millones de años.
No las podemos ver porque su tamaño es menor que la milésima parte de un milímetro (unidad llamada micra = μm). Debes dividir la milésima parte del metro mil veces más. Para entenderlo mejor, es como 50 veces más delgado que el grosor promedio de un cabello humano. Los microscopios ópticos de bajo aumento no logran verlas, pero si los más potentes y los electrónicos obviamente. Ahora en un cultivo en placas de Petri, hecho por un experto que no sea este autor en sus principios, se nota claramente las especies por el patrón que dejan en el gel o el medio de cultivo.
La biodiversidad bacteriana no está totalmente dilucidada ya que supera los dos millones de especies registradas, esto las convierte en los organismos más diversos, incluso por encima de los insectos. En la naturaleza, la riqueza de especies es favorecida por tamaño pequeño, antigüedad evolutiva y vida corta. De allí que una bacteria aislada de su medio ideal sin encapsularse, solo vive menos de medio día. Por ejemplo, la Chlamydia pneumoniae, que produce la tos común en niños humanos, solo vive 45 minutos en el aire, y el jabón o los ácidos débiles le son letales.
La propagación de las bacterias es sencilla ya que se reproducen asexualmente, es decir no hay una bacteria femenina ni una masculina, solo se dividen y ya. Esto hace que se produzcan decenas, centenas, miles y millones de clones en segundos. Aunque algunas bacterias pueden combinar material genético y así diversificarse, además de que entre tantas divisiones ocurren mutaciones que las harán más débiles o resistentes según las leyes de la evolución orgánica en el medio donde se encuentren que les sea favorable.
Las bacterias se parecen en algo a las células vegetales, y es que tienen pared celular que las protege del medio ambiente. Esta pared les da rigidez y formas como esferas llamadas cocos, bastones nombrados bacilos, en forma de coma que se conocen como vibrios y en tirabuzón o sacacorchos llamados espiroquetas. Cuando los cocos se agregan podemos tener especies como los Estreptococos o estafilococos. También la composición química y grosor de esa pared hace que se tiñan en las placas de Petri con colores distintivos al añadir la tradicional tinción del bacteriólogo danés Christian Gram.
Otra forma de clasificarlas es según su función o alimentación, de allí su importancia ecológica. ¿Qué rol juegan ellas en el medio donde se encuentran? Las bacterias también pueden vivir en lugares extremos para el resto de los seres vivos como las profundidades de los océanos, con altas presiones, sin luz, ni oxígeno. Esas bacterias de los abismos marinos son quimiosintéticas, viven del azufre, dióxido de carbono e hidrógeno de las chimeneas volcánicas a más de 100 hasta 400°C en un ambiente con una profundidad superior a los 2000 metros. Una especie descrita en California es Methanopyrus kandleri transforma CO2 en metano y en sus células se encuentran grasas que logran alimentar todo un ecosistema vecino.
Por otro lado, están las bacterias fotoautótrofas que viven de la luz en ambientes hipersalinos como las cianobacterias. Una de las más famosas bacterias verde azules es la Spirulina o Arthrospira, estas producen grandes cantidades de proteínas, carotenos, antioxidantes y vitaminas, por ello son cultivadas como fuente de estas sustancias vitales para la alimentación.
Con todo lo anterior prevalece la mala fama de las bacterias patógenas, que son una minoría dentro del gigantesco grupo de estos microorganismos. Sabemos la causante de la gonorrea Neisseria gonorrhoeae. El ántrax Bacillus anthracis, la super tóxica Clostridium botulinum que abunda en los alimentos mal enlatados o empaquetados.
Finalmente, no pensamos en los argumentos iniciales ni mucho menos cómo nos ayudan a digerir los alimentos siendo el caso de la Escherichia coli o el Lactobacillus acidophilus. Una terapia reciente para mejorar nuestra flora digestiva es tomar probióticos o bacterias liofilizadas como Bacillus claussi. Esperemos que luego de estas líneas cambiemos nuestra percepción de estos microbios. Igual no descuidar el aseo de lo que se acerque a nuestro cuerpo.